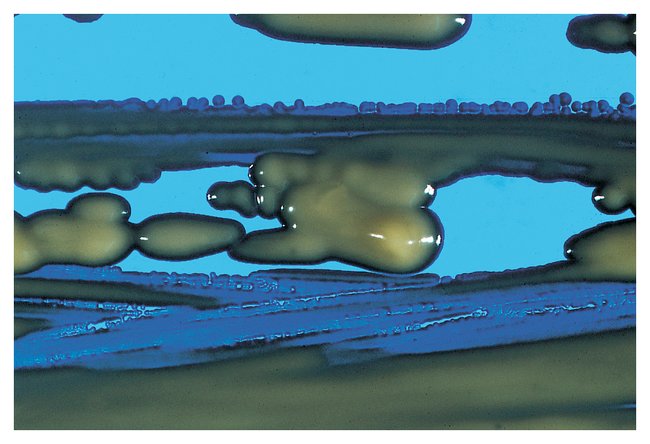

Carolina™ Individual Bacterial Cultures (D-M), Each
$ 20.93
|
|
Details:
Bacteria cultures have wide applications in the food and chemical industries because of their highly diverse metabolic activities.
Additional Information
| SKU | 10161653 |
|---|---|
| UOM | Each |
| UNSPSC | 60100000 |
| Manufacturer Part Number | 155155 |
